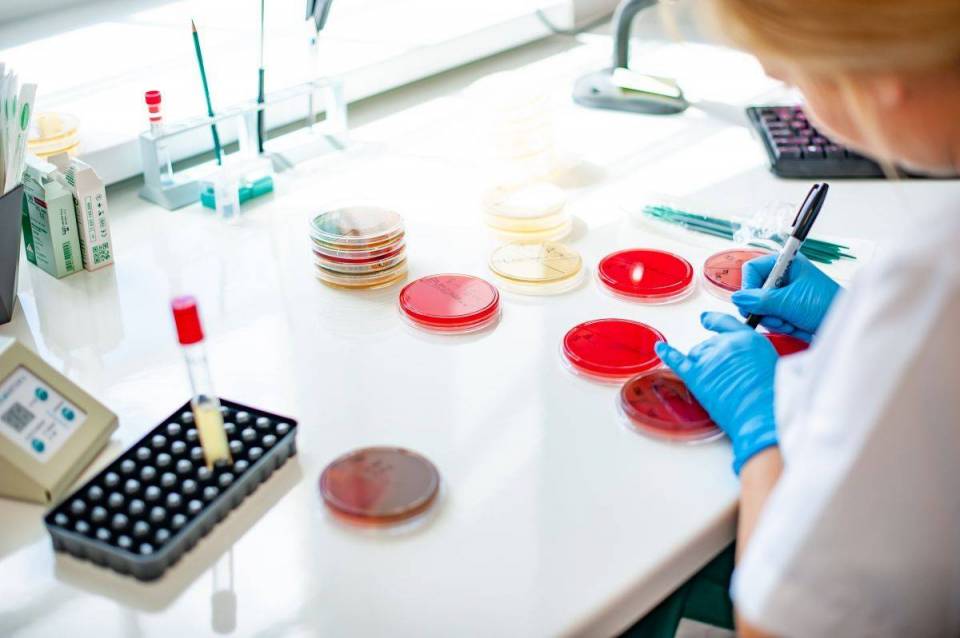

Najważniejsze wideo w ebr24

Jubileusz stulecia Ochotniczej Straży Pożarnej w Przyłęku Dużym oraz Powiatowy Dzień Strażaka
Liczba osób, które zobaczyły to wideo560 wyświetlenia
Nowy budynek Urzędu Gminy Sadkowice
Liczba osób, które zobaczyły to wideo7 255 wyświetlenia
Ochotnicza Straż Pożarna w Przyłęku Dużym, obchodzi w tym roku okrągłą - setną rocznicę
Liczba osób, które zobaczyły to wideo11 852 wyświetlenia
Gmina Nowy Kawęczyn i Powiat skierniewicki wspólnie realizują inwestycje drogowe
Liczba osób, które zobaczyły to wideo14 581 wyświetlenia
Funduszowy Maj – cykl darmowych wydarzeń organizowanych w całym województwie łódzkim
Liczba osób, które zobaczyły to wideo92 426 wyświetlenia
Skandaliczna i polityczna decyzja Banku Gospodarstwa Krajowego. Powiat ma stracić wiele milionów złotych!
Liczba osób, które zobaczyły to wideo23 996 wyświetlenia
Gmina Koluszki: Trwa rewitalizacja budynków przy ulicy Kolejowej
Liczba osób, które zobaczyły to wideo18 690 wyświetlenia
Gmina Koluszki: Wmurowanie kamienia węgielnego w nowym budynku SIM
Liczba osób, które zobaczyły to wideo22 129 wyświetlenia
Bitwa wodna w Lisowicach
Liczba osób, które zobaczyły to wideo24 464 wyświetlenia
Dzień Kobiet w Powiecie Skierniewickim
Liczba osób, które zobaczyły to wideo28 757 wyświetlenia
Dzień Kobiet w Gminie Głuchów
Liczba osób, które zobaczyły to wideo43 306 wyświetlenia
IV Powiatowy Dzień Kobiet w Rawie Mazowieckiej
Liczba osób, które zobaczyły to wideo33 665 wyświetlenia
Mateusz Morawiecki, Waldemar Buda i Marek Jakubiak w Głuchowie
Liczba osób, które zobaczyły to wideo47 075 wyświetlenia
Wyjątkowy turniej w Koluszkach
Liczba osób, które zobaczyły to wideo28 814 wyświetlenia
Starostwo w Rawie Mazowieckiej: Ważne spotkanie na temat chorób cywilizacyjnych
Liczba osób, które zobaczyły to wideo31 500 wyświetlenia
Szpital w Rawie Mazowieckiej w trakcie remontu. Dyrektor placówki zaprezentowała nam postęp prac
Liczba osób, które zobaczyły to wideo33 544 wyświetlenia
Turniej o Puchar Starosty Skierniewickiego
Liczba osób, które zobaczyły to wideo48 296 wyświetlenia
Gmina Głuchów: Uroczyste otwarcie Centrum Rozwoju Turystyki i Kultury w Kochanowie
Liczba osób, które zobaczyły to wideo52 224 wyświetlenia
Gmina Koluszki: Gala podsumowująca inwestycje w 2025 roku
Liczba osób, które zobaczyły to wideo33 535 wyświetlenia
Gmina Głuchów - koncert noworoczny
Liczba osób, które zobaczyły to wideo42 522 wyświetlenia
Gmina Nieborów: Biblioteka. Centrum Animacji i Kultury oficjalnie otwarte
Liczba osób, które zobaczyły to wideo41 110 wyświetlenia
Nieborów: Bibiloteka. Centrum Animacji i Kultury gotowy dla mieszkańców
Liczba osób, które zobaczyły to wideo36 293 wyświetlenia
Wigilia w Starostwie Powiatowym w Rawie Mazowieckiej
Liczba osób, które zobaczyły to wideo48 585 wyświetlenia